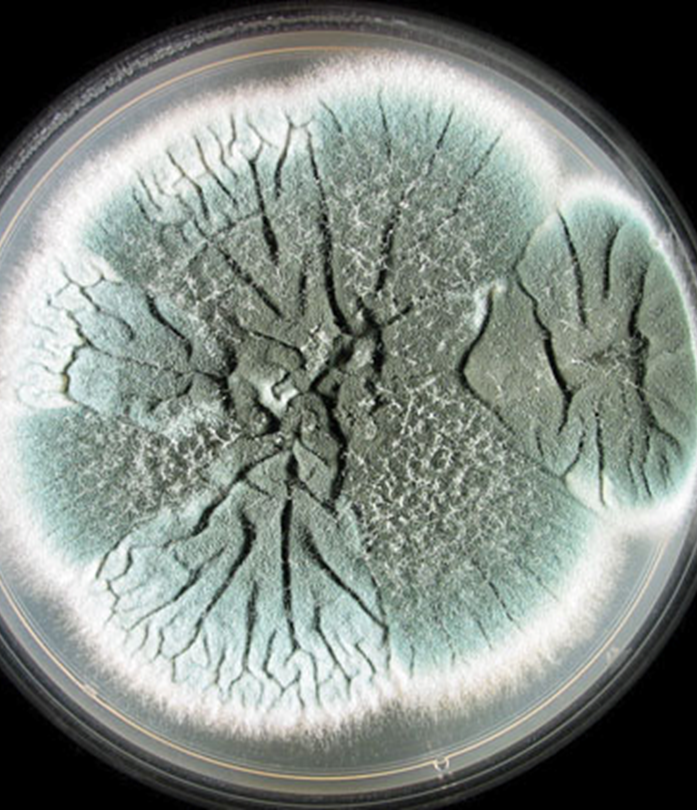
<p><em>Aspergillus fumigatus</em></p>
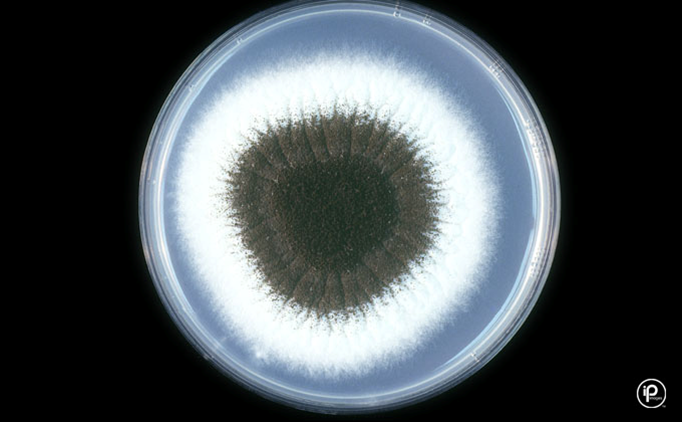
<p><em>Aspergillus niger</em></p>
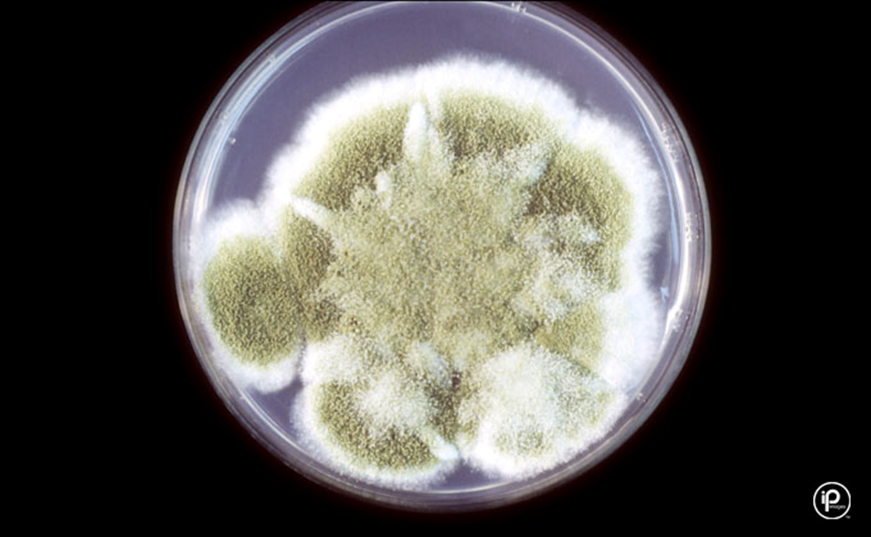
<p><em>Aspergillus flavus </em></p>
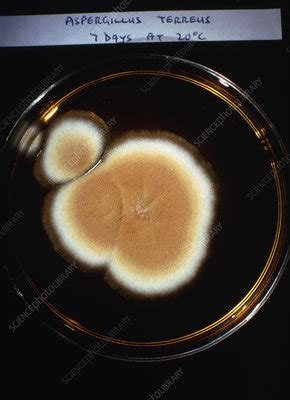
<p><em>Aspergillus terreus</em></p>
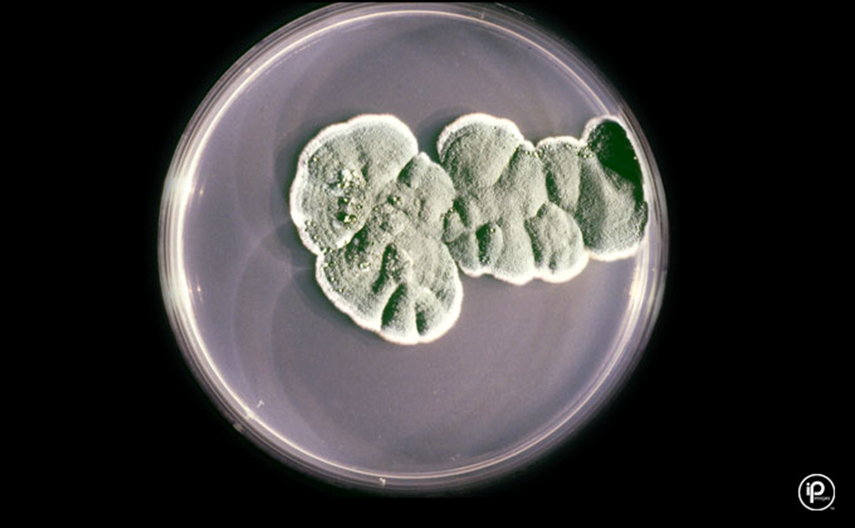
<p><em>Penicillium spp.</em></p>

1/11
Looks like no tags are added yet.
Name | Mastery | Learn | Test | Matching | Spaced |
|---|
No study sessions yet.
Aspergillus fumigatus
Hyaline/Septate
Blue-green/white
Uniseriate phialides on upper ½ to 2/3 of vesicle, round conidia
Most frequent isolated Aspergillus spp.

Aspergillus niger
Hyaline/Septate
Salt and pepper/white
Biseriate phialides all around vesicle, dark round conidia
Number one cause otomycosis

Aspergillus flavus
Hyaline/Septate
Yellow-green to khaki/white
Biseriate phialides all around vesicle, round conidia
Produces aflatoxins, toxicosis

Aspergillus terreus
Hyaline/Septate
Cinnamon-brown/white
Biseriate phialides on upper ½ of vesicle, round conidia

Penicillium spp.
Hyaline/Septate
Blue-green/white
Short phialides on metula, round conidia in chains, “brush-like”
Cutaneous, respiratory, external ear infections
